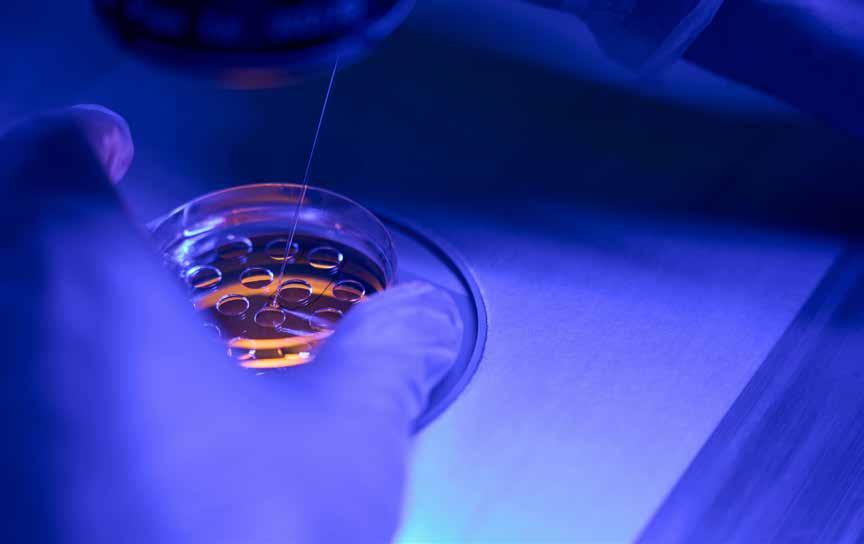

See
Oncology Research pg.3
Mental Health pg.6
Healthy Heart pg.7
The Framework pg.8
Financial Forecast pg.11

IVF Services Now Caught in The Crosshairs

 By Adrienne E. Frazior, J.D. Sidra S. Galvin, J.D. Polsinelli, PC
By Adrienne E. Frazior, J.D. Sidra S. Galvin, J.D. Polsinelli, PC
Recent legal developments in Alabama demonstrate that fertility care stakeholders should prepare for additional state regulation of in vitro fertilization (“IVF”) and other assisted reproductive technology (“ART”) services in states that have sought to restrict abortion access following the U.S. Supreme Court’s 2022 decision to overturn Roe v. Wade in Dobbs v. Jackson Women’s Health Organization (“Dobbs”).
The Alabama Supreme Court has long interpreted the state’s Wrongful Death of a Minor Act (the “Act”) to recognize the personhood of “unborn children.” In LePage v. Center for Reproductive Medicine, P.C. (“LePage”), a case involving a wrongful death action brought under the Act against a fertility clinic that inadvertently destroyed cryopreserved human embryos, the Alabama Supreme Court expanded the Act’s definition of “unborn children,” effectively providing that cryopreserved embryos are also persons and therefore covered under the Act. LePage has severely disrupted access to fertility care services in Alabama, where several health care providers have paused IVF and related services until further state guidance is issued. In fact, there is at least one pending lawsuit brought under the Act against a mobile fertility clinic.
LePage indicates that several states may be inclined to increase regulatory scrutiny of ART services

in the months and years ahead. ART regulation will likely be left to the states, rather than the U.S. Congress or U.S. Supreme Court, for two reasons:
(1) decisions such as LePage reflect a state supreme court’s final decision on a state police power, which the 10th Amendment to the U.S. Constitution protects as a sovereign state activity; and
(2) any proposed federal legislation that would encumber ART access in a manner similar to LePage is not likely to become law, because both presumptive presidential nominees in 2024 have stated their disagreement with the LePage opinion, and therefore either would be inclined to veto a proposed federal law to grant personhood to cryopreserved embryos. Nevertheless, fertility care stakeholders should pay close attention to pending state legislation and court decisions that could impact ART access.
The outcome of state law activity regarding ART regulation, particularly the personhood status of cryopreserved embryos, remains uncertain. Indeed, there appears to be a general divide among even conservative lawmakers and jurists on the question of whether cryopreserved embryos are persons for the purposes of state law.
For example, Alabama Supreme
Court Justice Mendheim concurred with the result in LePage but urged the state legislature to clarify the definition of “unborn child” under the Act, citing that the Act, which first became law in 1872, was enacted before “IVF was even a possibility.”
Further, although Alabama statutes and court precedents contain some of the narrowest legal exceptions for abortion services among the 50 states, Alabama state legislators have already amended state law with an eye toward preserving ART access. Shortly after the LePage decision, Alabama enacted SB 159, a bill to provide individuals and entities with civil and criminal immunity for the death of or damage to an embryo. However, while SB 159 arguably shields health care providers from civil and criminal prosecution, it does not regulate whether life begins at conception, nor does it grant civil immunity to “manufacturer[s] of goods used to facilitate the IVF process or the transport of stored embryos.”
Like Alabama, other states that have restricted abortion access are primed to more closely regulate ART services. States to watch include Idaho and Texas, two of the most abortion-
HOUSTON April Edition 2024 Volume 14 | Issue 4 PRSRT STD US POSTAGE PAID PERMIT NO 1 HOUSTON TX
Inaugural Match Day for SHSU-COM
pg. 10 Inside This Issue
Memorial Hermann Life Flight® Soars to New Heights with $5 Million Donation from ExxonMobil
12
See pg.
INDEX
see IVF Services ...page 14







medicaltimesnews.com April 2024 EXPLORE THE COMFORTS OF YOUR NEW HOME! SCHEDULE YOUR TOUR TODAY! HYCOHEN RESIDENCY APARTMENTS 13511 HYCOHEN ROAD HOUSTON, TX 77047 WWW.HYCOHENAPTS.COM (832) 699-4000 STATE OF THE ART GYM STAINLESS STEEL APPLIANCES BBQ GRILLING AREAS SCA N ME FAUX WOOD STYLE FLOORING WASHER/DRYER IN UNIT BRAND NEW CONSTRUCTION GRANITE COUNTERTOPS PRIVATE PATIOS W/STORAGE SPACIOUS & MODERN FLOOR-PLANS VEHICLE CHARGING STATIONS Welcome Home To Ask about medical employee discount
Oncology Research
When Your Cancer Returns: Understanding, Coping, and Moving Forward
 WhenBy Abhilasha Patel, M.D., Texas Oncology–Houston Willowbrook Radiation Oncology
WhenBy Abhilasha Patel, M.D., Texas Oncology–Houston Willowbrook Radiation Oncology
• Some cancer cells being left behind during initial treatment, or having spread to other parts of the body before initial treatment
• The development of treatmentresistant cancer cells over time
• Certain tumor characteristics, such as the ability to lie dormant for long periods

a patient reaches the end of cancer treatment and hears their physician say, “There is no evidence of disease,” it is a moment of celebration. But for some, being cancer-free is only temporary, and it may be a shock to learn your cancer has returned.
Cancer recurrence — the return of cancer after a period of remission — is a possibility for any cancer survivor. Whether it reappears in the same location or spreads to other parts of the body, navigating the challenges of recurrent cancer requires resilience, support, and informed decision-making with one’s medical team and loved ones.
• Using tobacco products, obesity, lack of exercise, and excess alcohol consumption can correlate with increased recurrence risk
Coping
The recurrence of cancer can evoke a wide range of emotions. A study to understand how cancer affects self-perception, body image, and mental and emotional health found that 70% of survey respondents experienced one or more symptoms of depression and 65% experienced anxiety.
Proactively addressing symptoms of depression or anxiety can help people cope more effectively with the

Understanding
According to the American Cancer Society, almost 1 in 2 men and 1 in 3 women in the U.S. are expected to face cancer in their lifetimes. Of the 18.1 million cancer survivors in the U.S. as of January 2022, some of these will face cancer more than once.
While the recurrence rates for specific cancer types are hard to measure long-term, what is known is that the likelihood of recurrence depends on the type and stage of cancer.
Cancer can recur in the same spot, in nearby tissues or lymph nodes, or it can appear in a completely different part of the body. Recurrence may happen due to:
emotional impact of cancer recurrence. However, the same study showed that only one-third of respondents sought out resources to help cope with physical and mental side effects of cancer treatment and only 25% sought resources for just mental side effects.
In addition to resources your care team may have available, self-care plays an important role in physical and mental health. Maintaining healthy habits can support both physical and emotional resilience, empowering patients to actively participate in their care journey. These may include:
• Consuming nutritious foods
• Engaging in exercise or physical
• Senior Associate Dean for Clinical Integration
• Assistant Dean for Graduate Medical Education
• Assistant Residency Director for Huntsville Family Medicine Residency
• Teaching Faculty of Osteopathic Principles & Practices/Physician
• Teaching Faculty of Clinical Medicine
• Primary Care Faculty for SHSU Physicians
• Director of Graduate Medical Education
• Director of SHSU Physicians
Houston Medical Times Page 3 medicaltimesnews.com April 2024
see Oncology ...page 14 Come grow with us as our faculty and staff expands. Located near The Woodlands, Texas, ranked #3 among the “Best Cities to Live in America” Received an A+ for schools, family friendliness, and jobs College of Osteopathic Medicine SAM HOUSTON STATE UNIVERSITY HIRING CLINICAL & TEACHING FACULTY shsu.peopleadmin.com Sam Houston State University is an Equal Employment Opportunity/Affirmative Action Employer and Smoke/Drug-Free Workplace. All qualified applicants will receive consideration for employment without regard to race, creed, ancestry, marital status, citizenship, color, religion, sex, national origin, age, veteran status, disability status, sexual orientation, pregnancy, or gender identity or expression. Sam Houston State University is an “at will” employer. Employees with a contract will have additional terms and conditions. Security sensitive positions at SHSU require background checks in accordance with Education Code § 51.215.
Hiring For:
Texas Children’s Dedicates Hospital Floor in Honor of Spirit of Children Charitable Foundation
By Texas Children’s Hospital
We are pleased to announce the name dedication of the Texas Children’s Hospital West Tower floor in honor of its long-time philanthropic partner, Spirit of Children.
The Spirit of Children Patient and Family Floor, located on the 16th floor of Texas Children’s Hospital West Tower, is a unique space where patients and families can gather and find Texas Children’s Art Studio, Child Life Zone, Classrooms, Kids Own Studio and more. Texas Children’s recently hosted a ceremony to unveil the new signage and pay tribute to Spirit of Children.
“We are excited to name a floor in honor of our long-time generous partner, Spirit of Children,” said Paige Schulz, Vice President of Patient Support Services at Texas Children’s Hospital. “Being in the hospital can
be hard for patients and their families — especially when they have to miss favorite holidays like Halloween — but thanks to Spirit of Children, we are able to bring some of that holiday fun to children who wouldn’t otherwise be able to celebrate.”
Texas Children’s Hospital has received close to 4 million dollars in donations from Spirit of Children since the start of its partnership in 2008. Texas Children’s, whose Child Life Team, collaborates with Spirit volunteers, hosts numerous fun activities for children each year and turns some events into parades to bring the excitement directly to patients in beds. The Child Life Department at Texas Children’s, working as part of a comprehensive health care team, strives to alleviate stress and to support patients as they


adjust to the hospital experience by providing developmental, educational and therapeutic interventions — music therapy, animal-assisted therapy and art therapy, among others.
“Partnering with the Spirit of Children campaign has been transformational for our team,” said Mary Tietjens, Assistant Director of Clinical Support Services in the Child Life Department at Texas Children’s.
“Due to the incredible passion of our Spirit of Halloween Associates, the
Child Life Department has all the resources needed to not only educate and support our patients but also bring them joy.”
Every October Texas Children’s Hospital Child Life Department is able to provide thousands of Halloween costumes, decorations, celebration kits and everything needed to bring parties to children who cannot leave the hospital. Spirit of Children – Spirit see Texas Children’s ...page 13





Houston Medical Times Page 4 medicaltimesnews.com April 2024
The Main Street Stars program is available at any D.R. Horton Community across Houston to individuals currently employed as military personnel, law enforcement personnel, firefighters, healthcare professionals and educators. Program offers up to $1,000 in closing costs or a $1,000 Options allowance. Availability of upgrades subject to stage of completion. Upgrades must be installed prior to closing. Buyer must contract between January 1 - December 31, 2024 to receive the incentive and present proof of employment (such as a pay stub or military ID card-active duty or retired) at time of contract execution. Homes must close within 10 days of completion as determined by the Builder (within 5 days of completion for Express Homes) to receive incentive. Program subject to cancellation or change without notice or obligation. See sales agent for complete details. Financing for South and Central Houston communities offered by DHI Mortgage Company, Ltd. (DHIM), 6744 Horton Vista Drive, Suite 200, Richmond, TX 77 407, Branch NMLS 196971, Company NMLS 14622. DHIM is an affiliate of D.R. Horton. For more information about DHIM Licensing and its affiliation with D.R. Horton please visit http://www. dhimortgage.com/affiliate/ Provided for informational purposes only. This is not a commitment to lend. Not all borrowers will qualify. The Main Street Stars program incentive is available with the use of any lender. Offer is valid on new contracts and does not apply to transfers, cancellations, or re-writes. Prices, plan, features, options and co-broke are subject to change without notice. No cash value; limit of one Main Street Stars incentive per home purchase. Incentive only available on full price offers. This promotion may not be available to buyers purchasing homes as investment property; please contact the community sales representative for details. Terms and conditions apply. Equal Housing Opportunity. New Homes from the Upper $200s Set an appointment to tour your new home today! CENTRAL & SOUTHEAST HOUSTON NEW HOMES 281-801-9395 | houstonsoutheastosc@drhorton.com Your New Life Starts Here! Thank you for your part in serving our community! We’re offering Healthcare professionals up to $1,000 toward closing costs or options allowance.
SHSU-COM Welcomes New Clinical Training Partners
By Mikah Boyd
The Sam Houston State University College of Osteopathic Medicine (SHSU-COM) is pleased to announce a new clinical partnership with the Ibn Sina Foundation and OakBend Medical Center to train medical students and residents in Fort Bend County. Beginning August 2024, the Ibn Sina Foundation and OakBend Medical Center will partner with SHSU’s College of Osteopathic Medicine to train third and fourth year medical students. The partnership will also begin the process to develop new graduate medical education programs in primary care medicine.
For the past 24 years, Ibn Sina Foundation clinics have been providing preventative and primary health services for a growing population of low income, uninsured and medically underserved families. Named after the eleventh century Persian physician and philosopher who is widely regarded as the father of early modern medicine,
the non-profit foundation has provided integrated preventive and primary care at affordable prices to all who seek it, treating every individual with dignity and respect.
OakBend Medical Center was founded in 1950 as Polly Ryon Memorial Hospital. The name was changed to OakBend Medical Center in 2004 and it has expanded to three locations. OakBend has continued its 75-plus year commitment to the health and wellness of the local community as the only remaining independent non-profit hospital in the Greater Houston area.
“SHSU-COM trains students in clinical sites in rural, urban underserved and community-based settings where there is a need for primary care physicians. Clinical partnerships are integral to osteopathic medical education,” said Thomas J. Mohr, DO, dean of SHSU-COM. “The Ibn Sina/ OakBend clinical training region of Sam Houston State University College of Osteopathic Medicine is a collaboration that will leverage the

strengths of each partner aligned with their shared missions to expand access to high-quality healthcare for those in need.”
Initially, the Ibn Sina Foundation explored the creation of a new osteopathic medical school to train see SHSU-COM ...page 14

Houston Medical Times Page 5 medicaltimesnews.com April 2024
IMPORTANT INFORMATION All surgery carries risk. Talk to your doctor to see if joint replacement is right for you. MKOSYM-PM-16_24378 Copyright © 2020 Stryker Learn more at houstonmako.com Hip or knee pain? Mako SmartRobotics™ for joint replacement helps you get back to the things you love, quicker.
Thomas J. Mohr, DO, dean of SHSU-COM
Mental Health
When You Have Been Hurt…
 By Michael Jones Ph.D
By Michael Jones Ph.D
The 3Rs of Recognition, Remorse, and Repair offer a valuable framework for navigating the aftermath of being hurt. We discussed before about the importance of forgiveness for your own sake. But how to decide about being vulnerable again when someone hurts you? Forgiveness is not enough. Consider the 3Rs: recognition, remorse, and repair. This approach underlines the importance of acknowledging harm, expressing genuine regret, and taking actionable steps towards making amends.
• Recognition: The first step involves acknowledging the hurt caused, an essential part of healing and moving forward. It requires
the person who caused the harm to fully understand the impact of their actions on the other. This isn’t just about admitting a mistake; it’s about deeply understanding how the actions have affected someone else, showing empathy and awareness. It’s like saying, “I see the pain I’ve caused, and I understand it.”
• Remorse: Genuine remorse goes beyond a simple apology. It’s about expressing sincere regret for the harm done, not just for the consequences one faces as a result of their actions. This step is crucial for the person hurt to feel that their pain is recognized and validated. It’s an emotional expression that says, “I truly regret the pain I’ve caused you.”
• Repair: This final step is about taking action to make amends and address the damage caused. Repair can take many forms, depending on the situation and the needs of the person hurt. It might

involve a direct action to rectify the situation, a commitment to change behavior, or other efforts to restore trust and rebuild the relationship. It’s a commitment to action, demonstrating, “I am willing to make things right.”
If you don’t get 3 out of 3 it is unwise to be emotionally vulnerable. The person is likely to hurt you again. So, practice forgiveness but pay attention to the 3Rs. Now, have a great rest of the day.


Houston Medical Times Page 6 medicaltimesnews.com April 2024
Healthy Heart
Heart Disease Doesn’t Have to Keep You From Donating Blood
By The American Heart Association
As blood centers and hospitals face critically low levels of blood supplies, many people with heart disease may wonder if they can help by donating.
For the most part, they can do so safely, experts say.
Typically, someone in the U.S. needs blood about every two seconds for reasons that may include surgery, cancer treatments, childbirth, anemia, serious injury or blood disorders.
In fact, a surprising number of potential blood donors are those with a history of medical conditions, including heart disease, who remain steadfast in their desire to give blood, said Dr. Alcinda Flowers, medical director of Versiti, a Milwaukee-based blood center.
“They’re often the ones that want to donate because they’ve been in the hospital and they’ve been affected
themselves by the need for blood,” she said. “And they can empathize with others.”
Every year, more than 11 million units of whole blood are donated in the U.S., according to the Food and Drug Administration. However, only about 3% of eligible individuals donate blood, says the American Red Cross, which in January reported an emergency blood supply shortage after reaching a 20-year low in the number of donors. Winter storms and a surge in COVID-19 cases likely further disrupted supplies.
The FDA regulates the safety of blood products primarily to protect blood recipients, and donation requirements may vary at blood centers.
Blood centers screen all potential donors with a questionnaire to determine which people can safely give blood, Flowers said.
According to the National Institutes of Health, people with a

cold or the flu can’t donate blood until they have been symptom-free for 48 hours, with different limitations for COVID-19 and other conditions.
However, people who have heart disease can be considered for blood donation, Flowers said.
In addition, most people with high blood pressure, or hypertension, can donate blood and do so if their systolic blood pressure (top number) is below 180 millimeters of mercury and diastolic (bottom number) is 100 mmHg at the time of donation.
The Red Cross recommends a six-month wait or longer for those who have had a heart attack, a recent
episode of angina, bypass surgery or angioplasty, or if a change in their heart condition resulted in a medication change.
People who use blood thinners or other anti-clotting or antiplatelet medications must disclose all their medications during their health screenings because donating blood may be harmful to them, as well as the recipients, Flowers said.
Bottom line: It’s a good idea for those with heart conditions to check with their health care team before donating blood, Flowers said.


Houston Medical Times Page 7 medicaltimesnews.com April 2024
713 835 0050
+1
Parc Binz II is a 5-story Class “A” boutique, office/medical building. The floorplates are approximately 8,600 SF where a tenant can have full floor privileges with minimal square footage. The building features 4,672 SF of retail space on the first floor, to include fast casual concepts, along with surface, garage, and underground parking. Museum District Medical Building 1802 Binz St
Doug Pack | Sam Hansen
RecentlyCompleted NowLeasing



The Menninger Clinic announced the opening of its new Center for Addiction Medicine and Recovery, which specializes in treating substance use and behavioral addiction that may be accompanied by a mental health issue. With a growing number of people living with substance use disorders and addictions, the new center allows Menninger to expand its practice of simultaneously treating a patient’s addiction and other psychiatric conditions, leading to improved long-term outcomes.
“A growing number of people are living with substance use disorders and addictions, and
sex addiction, gambling, spending or other processes that cause significant consequences. Featuring the latest options, Menninger’s addiction treatment services include:
• Evidence-based treatments, including safe, effective detoxification, medications, cognitive behavioral therapy, dialectical behavior therapy, mentalization-based therapy, acceptance and commitment therapy, medicine-based abstinence and harm-reduction programs;
• Recovery coaching services with certified peer recovery specialists who share their

this new center expands our ability to offer patients innovative and effective treatment options that lead to better outcomes,” said Armando E. Colombo, president and CEO, The Menninger Clinic. “The vision for this new center is now a reality thanks to the many donors and mental health advocates who supported our efforts to create this facility.”
The new center is located on the second floor of Menninger’s Outpatient Services Center in 8,300 square feet of space that includes 10 therapy rooms, an observation suite for training addiction professionals, a medication suite, two group meeting rooms and a patient activity room.
Menninger’s new Center for Addiction Medicine and Recovery treats substance use disorder as well as behavioral addictions, such as
personal experiences in recovery to support and encourage others on their recovery journeys;
• Recovery Intensive Outpatient Program (IOP), a six- to eight-week program that integrates services for substance use, addiction and co-existing mental health conditions;
• Navigator, a collaborative case management program with coaching and peer support that helps adults maintain their recovery from drugs and alcohol plus any mental illness, to reduce recurrence of substance use or a mental health crisis after returning home;
• The opportunity to participate in a scientific study of an
Houston Medical Times Page 8 medicaltimesnews.com April 2024
Menninger Clinic
Center for
Professional Science Master’s UNCONVENTIONAL Career
Learn more profms.rice.edu APPLIED CHEMICAL SCIENCES BIOSCIENCE & HEALTH POLICY ENVIRONMENTAL ANALYSIS ENERGY GEOSCIENCE SPACE STUDIES Develop advanced technical and professional skills to make a difference in your career! see The Framework...page 13 Dear Doctors and Staff, Let us take the guesswork out of fracture referrals. No more waiting for appointments! We at the Orthopedic Care Center wish to offer your patients and staff easy scheduling of patients. Our office has extended office hours on Fridays to accommodate patients with fractures. On behalf of the Orthopedic Care Center Lubor Jarolimek M.D. ORTHOPEDIC CARE CENTER 2121 OAKDALE HOUSTON, TX 77004 Call us today! Call us today! OCC_FractureFridaysFA3_Outlined.indd 1 5/29/2013 7:20:41 PM
The
Opens New
Addiction Medicine and Recovery The Framework
Path






Houston Medical Times Page 9 medicaltimesnews.com April 2024 Ft. Bend Pkwy . GALLERIA TEXAS MEDICAL CENTER Exxon Mobil HQ NASA FM 518 Sienna Meridiana Del Bello Lakes Ha r dy T oll Road Evergreen Wood Leaf Reserve Woodhavyn SCAN ME Learn more about Shea Homes in the Greater Houston Area sheahomes.com/Houston Del Bello Lakes 60’ From the $450s Meridiana 70’ From the $550s Sienna 40’ From the $390s Sienna 65’ From the $500s This is not an offer of real estate for sale, or a solicitation of an offer to buy, to residents of any state or province in which registration and other legal requirements have not been fulfilled. Pricing does not include options, elevation, or lot premiums, effective date of publication and subject to change without notice. All square footages and measurements are approximate and subject to change without notice. Trademarks are property of their respective owners. Equal Housing Opportunity. WELCOME TO WOW Prepare to be WOWED
SHSU-COM’s Inaugural Class of 2024 Sets a High Bar For Texas’ Newest Osteopathic Medical School
By Luanne Brownd
A99% Match rate and 100% residency placement by the inaugural Class of 2024 has placed Sam Houston State University College of Osteopathic Medicine (SHSU-COM) firmly in the Texas and U.S. medical landscape. Following a May 9 graduation, Texas’s newest osteopathic medical school will receive full accreditation and a major milestone in the mission of providing primary care to rural and community-based sites will be realized.
“You are trailblazers, and frankly, if you hadn’t performed at the level that you did, it would be much more difficult for the students who follow to find their matches,” said SHSU President Alisa White at the March 15 Match Day Celebration at The Woodlands Resort. “Some of you are going all over the U.S., and some of
you are going home. I hope that some of you who are not from Texas, but now call Texas home, come back and serve, because we need you here. There is a shortage of medical providers here, and you can help make a difference.”
Thomas J. Mohr, DO, Dean of SHSU-COM said, “This inaugural Match Day is the culmination of years of work on the part of the faculty, staff and clinical preceptors who have developed SHSU-COM as a new medical school with a solid curriculum and an outstanding network of community-based physicians dedicated to training the next generation of physicians. More importantly, this day highlights the incredible tenacity, tireless studying and long hours of patient care dedicated by our students to pursue their lifelong dream of becoming doctors. We are so proud of them and all their efforts – they have worked so hard to get to this point.”

Student doctor Ammie Rupani from Sugarland, Texas, explained the anticipation of receiving her match as she hoped to remain close to her family and serve local Houston communities in need.
“Your hands are shaking when you’re opening that envelope, and there are butterflies times ten,” she said referring to the synchronized national countdown for medical students
awaiting discovery of their residency match. “You can’t even see properly because your vision is so blurry. You have to look at the letter to see where you matched. It’s surreal.”
A wave of relief washed over Rupani when her envelope revealed her match as the University of Texas Medical Branch in Galveston, an
see Class of 2024...page 13

Houston Medical Times Page 10 medicaltimesnews.com April 2024
The Inaugural Class of Sam Houston State University College of Osteopathic Medicine had a 100% residency placement with 58% proudly serving residencies in the Lone Star State. 68% of class residency placements are in Primary Care, helping SHSU-COM drive forward its mission of providing primary care in rural and underserved areas of Texas. Photo Credit: Maggie Cheatham
Financial Forecast
Home Ownership for Unmarried Couples Legal and Financial Keys to Consider
 By Grace S. Yung, CFP Midtown Financial Group, LLC
By Grace S. Yung, CFP Midtown Financial Group, LLC
Home ownership has always been considered part of the American Dream. For many couples – whether married or unmarried – a key component of building a life together is attaining and maintaining a home. In some cases, however, a happy home may start to crumble if unexpected issues like death or disability occur. With that in mind, it is critical to put
expenses of the survivor or healthy partner.
Additionally, if one partner becomes ill and requires financial assistance from Medicaid, this could also have implications on the home. For example, in Texas, in order to exempt the home from the assets that Medicaid has access to, if there is no spouse living in the home, there is a home equity limit of $713,000 (in 2024). (Source: https://www.medicaidplanningassistance.org/medicaid-eligibility-texas/)
Plus, even if the home is exempt from Medicaid’s asset limit, it may not be exempt from the Medicaid Estate Recovery Program. In this case,

precautions in place that will protect both parties to prepare for unforeseen circumstances.
Risks to Your Home Sweet Home
Unfortunately, fire, natural disasters, and theft aren’t the only risks that you can face with your home. In fact, some “unseen” perils could even pose more of a threat, particularly if you and your partner reside in the home together.
These risks can include:
Death of a partner
Disability or incapacity of a partner
Ending of the relationship
Unexpected incidents can and do occur so it is essential that you are prepared legally and financially to protect your home and each other.
For example, today, many households have two income earners, and the loss of one of these income streams due to death or disability can make it difficult or impossible to pay for housing costs and other essential living



following the death of a Medicaid recipient, the Texas Medicaid agency will attempt to obtain reimbursement for its costs of care from remaining assets of the decedent – including his or her home. (Source: https://www.medicaidplanningassistance.org/medicaideligibility-texas/) Without protection in place, this situation could force the surviving partner to move out of the home.
It is also possible that, in the event of one partner’s death, his or her blood relatives may take over ownership of the property, based on the laws of inheritance. This could pose a significant threat to the surviving partner who risks losing his or her home.
Building a Wall of Legal and Financial Protection Around Your Abode


Houston Medical Times Page 11 medicaltimesnews.com April 2024 PRT-00000-0000 Tracking #0-000000 (Exp. 00/00) The Financial Consultants at <DBA Name> are registered representatives with, and securities and advisory services are offered through LPL Financial (LPL), a registered investment advisor and broker-dealer (member FINRA/SIPC). Insurance products are offered through LPL or its licensed affiliates. [Credit Union name] and [DBA name] are not registered as a broker-dealer or investment advisor. Registered representatives of LPL offer products and services using [DBA name], and may also be employees of [credit union name]. These products and services are being offered through LPL or its affiliates, which are separate entities from, and not affiliates of, [credit union name] or [DBA name]. Securities and insurance offered through LPL or its affiliates are: DBA Name Located at Institution Name Agent Name, Desig 1, Desig 2, Desig 3, Desig 4 Title 1 Title 2 or Insurance Lic#xxxxxxxx Address line 1 Address line 2 City, State XXXXX (000) 000-0000 xExt or Description (000) 000-0000 xExt or Description (000) 000-0000 xExt or Description email.address@email.com www.webaddress.com Your Logo Here Not Insured by NCUA or Any Other Government AgencyNot Credit Union GuaranteedNot Credit Union Deposits or Obligations May Lose Value PROOF LOCKUP A V2 MKT-06048-0122 Tracking #1-05228930 A successful retirement in the future can often depend on having a solid plan now. If your money isn’t working as hard as you are, it may be time to act—there are no do-overs in retirement planning. Now is the time to consider developing a strategy that can help you work toward your financial goals. I specialize in providing comprehensive, personalized financial guidance with the goal of maximizing every remaining moment of the retirement countdown. PLAN WISELY. YOU WON’T GET A DO-OVER. Call today to learn more or to schedule a consultation. S laicnaniF nwotdiM dna laicnaniF LPL .CPIS/ARNIF rebmeM ,rosivda tnemtsevni deretsiger a ,laicnaniF LPL hguorht dereffo secivres yrosivda dna seitiruce G.seititne etarapes era CLL ,puor nwotdilaicnaniF,puorGCLLM G.SecarYgnu,C®PF MrotceriD gnigana 3081 .etS ,.tS amabalA 553 Hnotsuo TX 7 8907 7 3389-553-31 O ecfif 1 9683-464-558- T eerF g moc.lpl@gnuy.ecar wmoc.gfnwotdim.ww
see Financial Forecast...page 13 PIERSON COMMERCIAL A REAL ESTATE CO MPANY COMMERCIAL REAL ESTATE SERVICES DOWNSIZING RELOCATING RENEWING Our professionals specialize in negotiating the best economical solution for our clients. We can help value, market and sell your property! ► www.piersoncommercial.com ► 281.915.7049 ► john@piersoncommercial.com ►John DelaRosa Principal/Broker
Memorial Hermann Life Flight Soars to New Heights with $5 Million Donation from ExxonMobil
By Memorial Hermann
TheMemorial Hermann Foundation is pleased to announce that ExxonMobil has generously donated $5 million to Memorial Hermann Life Flight to support a newly launched $55 million campaign to fund the purchase of four new helicopters and a specialty aircraft to replace the current, aging fleet.
“Life Flight has provided critical emergency care for nearly 50 years. We’re proud to be part of this impactful initiative,” said Alvin Abraham, global manager of corporate giving at ExxonMobil.
“ExxonMobil is committed to investing in opportunities that improve community health and safety. We’re excited about bringing Life Flight one step closer to its goal.”
The new fleet – expected to take flight in 2025 – will expand Life Flight’s service area to a 250-mile radius of Houston’s Texas Medical Center (TMC) to serve more people in need of critical air ambulance transport. ExxonMobil’s $5 million gift will support the entire fleet and will be recognized on one of the new H145 helicopters which will have larger cabin and cargo space, enhanced technology and safety features, increased fuel load and shorter reconfiguration times — providing the capabilities of an intensive care unit in the sky.
“Over the course of my career, I have had the true privilege of partnering with ExxonMobil as it furthers its work in support of our Greater Houston community,” said Anne Neeson, executive vice president

and CEO of the Memorial Hermann Foundation. “This incredibly generous gift from ExxonMobil will help ensure that Memorial Hermann Life Flight can continue serving the needs of our community now and well into the future. Philanthropy from individuals, families and companies like ExxonMobil is crucial to support this community resource that plays such an integral role in saving lives in Southeast Texas.”
A service provided by Memorial Hermann Health System, Life Flight operates as a hospital-based, nonprofit
organization and relies on community support and fundraising efforts to pay for the service. Founded in 1976 by James “Red” Duke, MD, Life Flight currently serves the community within a 150-mile radius of the TMC with helicopters and worldwide using fixed-wing transport. Life Flight has flown more than 166,000 missions since its inaugural flight.
ExxonMobil made a prior $1 million donation and provided three engines to support Life Flight’s current operating fleet.

Houston Medical Times Page 12 medicaltimesnews.com April 2024
Anne Neeson, executive vice president and CEO of the Memorial Hermann Foundation, and Alvin Abraham, global manager of corporate giving at ExxonMobil.
You can get the Houston Medical Times delivered straight to your inbox. Never miss an Issue of Houston’s Leading Local Healthcare News Online. Subscribe to Our Digital Issue medicaltimesnews.com
Texas Children’s
Continued from page 4
Halloween’s charitable foundation –donates all these items in addition to a yearly monetary donation.
“We could never have imagined
The Framework
Continued from page 8
innovation in treatment.
Medical Director Daryl Shorter, MD, leads the center which includes a team of 25 staff members, including addiction psychiatrists, licensed addictions counselors and certified peer recovery specialists. In addition to onsite treatment, community-based
Class of 2024
Continued from page 10
area that provides a free clinic she is passionate about.
During the past four years, SHSU-COM has steadfastly accomplished its mission of providing healthcare in rural East Texas and underserved Texas communities as third and fourth year students have served clerkships in these and other locations in the COM’s continually expanding network of clinical partnerships.
Student doctor Megan Johnson, who will complete her Army scholarship path to becoming an OB-GYN at Brooke Army Medical Center in San Antonio, is proud of the impact she and her peers have made in the local communities they served during the past two years of clerkship rotations. “SHSU-COM’s efforts will
the impact Spirit of Children would have when we first started this program, but through the incredible efforts of our team and guests, we have seen
many magical moments shine a bright light on what’s often a dark and scary time in children’s lives,” said Richard Tereo, Director, Spirit of Children Foundation.
treatment teams composed of clinical trainees, counselors and peer recovery specialists will provide addiction services in underserved areas throughout the region.
“A core tenet of Menninger’s addiction treatment is emphasizing that substance use disorders exist
alongside mental health conditions and dispelling the notion that mental health conditions drive substance use disorder,” said Shorter. “The new Center for Addiction Medicine and Recovery allows us to further incorporate this belief into practice through treatment, education, research and community outreach.”
For more information about The Menninger Clinic and available services, please visit www.menningerclinic.org or call 713-275-5400.
provide doctors to fill in Texas regions that could potentially be left without physicians when the current doctors retire,” she said.
Student doctor Kyle Swanson, who was born and raised in Conroe just across the street from where he attended medical school at the state-of-the-art
SHSU-COM building, matched to an orthopedic surgery residency at Ascension MaComb-Oakland Hospital in Michigan. He already left his Texas home once for a collegiate baseball career at Northwestern State University in Louisiana before returning to Montgomery County as a member of the SHSU-COM’s inaugural class. Swanson, as part of the three percent of his cohort to match in orthopedic surgery, upholds the COM’s success in not only providing primary care to
Financial Forecast
Continued from page 11
In addition to obtaining homeowners insurance to help ease the financial consequences of damage or theft, there are other items you should have in place to protect yourself and your partner from financial devastation in case of death, incapacity, or an end of the relationship.
These protections should include:
Life Insurance
Disability Insurance
− Long-term Care Insurance
Put an agreement in writing is a must for protecting yourself and making sure that the property is divided fairly in the event of a future break up. This “cohabitation agreement” should ideally cover:
What happens to the home in the event of a breakup?
The percentage of profits each partner will receive upon the sale of the home
rural and community-based sites, but also in expanding the opportunities for healthcare across the country in all specialties.
“These men and women decided they were going to put their faith in an untested, unknown, unheard of medical school because they believed they were going to be able to make a difference in the world,” Mohr said. “They believed they were going to be able to put their fingerprints all over a new institution, and they have. SHSU-COM will always be a reflection of this class.”
“The first class came through strong in moving our mission forward. I’m thrilled to say that 62% of the class is following primary care and 58% will be serving residencies in the Lone Star State. We’ve done our best to move our mission forward,” Mohr said to the
− Type of ownership on the home’s deed or title
How housing expenses will be shared
Dispute resolution process in case of a split
Retitling the home to either joint tenants or joint tenants with rights of survivorship could also be an option to protect unmarried partners who own a house. Going this route can allow the property to bypass probate if one partner passes away.
medical students. “It is your torch to bear moving forward.”
“I look forward to seeing you again on May 9, when I get to shake your hand, and for the first time, call you doctor.”
Is Your Home Protected from Unseen Dangers?
To make sure that you haven’t left any legal or financial “gaps” in protecting your home, talking with a CERTIFIED FINANCIAL
PLANNER™ professional can help. This can also help you to better anticipate potential tax, legal, and financial consequences, and put a plan in place to protect yourself and your partner.
Houston Medical Times Page 13 medicaltimesnews.com April 2024
IVF Services
Continued from page 1
restrictive states in the country. These states have introduced legislation that would increase regulatory scrutiny of ART, although not necessarily prohibit the practice of ART altogether. For example, Idaho House Bill 400 (2024) would “redesignate” the term “embryo” to “preborn child,” but qualify in its criminal statutes that a preborn child is “in utero.” Further, in its most recent legislative session, Texas lawmakers
Oncology
Continued from page 3
activity within one’s abilities
• Incorporating stress management techniques
• Adding integrative therapies such as meditation or massage Moving Forward
When facing cancer recurrence, weigh treatment options carefully and make informed decisions on the next step of your journey.
Considerations such as the type and location of the cancer, overall health status, treatment tolerance, and even personal preferences play a central part in the decision-making
SHSU-COM
Continued from page 5
physicians who would serve these populations in Greater Houston, according to Founder and Chairman Nasruddin Rupani. Following a year-long investigation, the decision was made to partner with SHSU-COM to place third and fourth year medical students in Fort Bend County. SHSU-COM opened in 2020 and will graduate its inaugural cohort of future physicians in May. The foundation’s goal for the partnership is to establish a clinical training region where student doctors are trained while simultaneously serving an area in
introduced legislation that would amend existing law that criminalizes an act against “an unborn child at every stage of gestation from fertilization until birth.” In particular, the bill would change the word “gestation” to “development.” If the bill had been enacted, this shift would have arguably provided a basis to criminally prosecute an act that harms a cryopreserved embryo, because “gestation” could be
read to apply to only those embryos in utero, whereas “development” could be interpreted to mean any embryo that exists, whether it is implanted in a uterus or not.
The bottom line of the LePage decision and analogous statutory law in various states is this: In the post-Dobbs era, some state lawmakers intend to more closely regulate the fertility care industry.
process. That is why an open dialogue with the healthcare team is essential to understand treatment goals, potential benefits, side effects, and overall outcomes.
Navigating cancer recurrence also requires a strong support network and access to reliable resources. Support groups, counseling services, and online communities offer opportunities for connection, empathy, and shared experiences with others who are going through a similar scenario.
While the prospect of cancer recurrence may evoke feelings of fear,
anger, or uncertainty, it’s also good to remember that feelings of hope and resilience can coexist. By understanding the nature of recurrence, addressing the emotional and practical concerns to cope with the diagnosis, and actively engaging in treatment decisions, one can navigate the journey of cancer recurrence with support, strength, and perseverance.

critical need of healthcare workers.
“It’s a win-win scenario for each of our organizations,” Mohr said. “OakBend Medical Center and Ibn Sina Clinics provide a range of excellent healthcare services including primary care, emergency medicine, women’s health, mental health services and will provide medical education opportunities under the guidance of clinical preceptors. Our student doctors assigned to the Ibn Sina/ OakBend clinical training site will move to Fort Bend County for their final two years of medical school and
become embedded in the community. We hope they will set down roots and decide to stay when their training is complete, thus providing a pipeline for future healthcare providers.”
Houston Medical Times Page 14 medicaltimesnews.com April 2024 HOUSTON Published by Texas Healthcare Media Group Inc. Director of Media Sales Richard W DeLaRosa Senior Designer Jamie Farquhar-Rizzo Web Development Lorenzo Morales Distribution Bell Distribution Accounting Liz Thachar Office: 713-885-3808 For Advertising advertising@medicaltimesnews. com Editor editor@medicaltimesnews.com Scan to Visit medicaltimesnews.com Houston Medical Times is Published by Texas Healthcare Media Group, Inc. All content in this publication is copyrighted by Texas Healthcare Media Group, and should not be reproduced in part or at whole without written consent from the Editor. Houston Medical Times reserves the right to edit all submissions and assumes no responsibility for solicited or unsolicited manuscripts. All submissions sent to Houston Medical Times are considered property and are to distribute for publication and copyright purposes. Houston Medical Times is published every month P.O. Box 57430 Webster, TX 77598-7430

Houston Medical Times Page 15 medicaltimesnews.com April 2024 Content on the Texas Health Steps Online Provider Education website has been accredited by the Texas Medical Association, American Nurses Credentialing Center, National Commission for Health Education Credentialing, Texas State Board of Social Worker Examiners, Accreditation Council for Pharmacy Education, and UTHSCSA Dental School Office of Continuing Dental Education. Continuing Education for multiple disciplines will be provided for some online content. Learn more at TXHealthSteps.com Join 250,000+ professionals who get free Continuing Education (CE) with Texas Health Steps Online Provider Education. Choose from over 50 CE courses developed by trusted Texas experts, for experts like you. Quick courses and case studies on topics such as Medicaid guidelines, ethics and mental health, and more are all available 24/7. Your one stop for Texas Health Steps Checkup resources. Screening tools, requirements and more, 24/7.







April 2024 Houston Medical Times medicaltimesnews.com
|
|
Brandy Bellow Spinks
Senior Vice President
+1 713 577 1642 | brandy.bellow@cbre.com
|
Angela Barber
|
Vice President
+1 713 577 3818 | angela.barber@cbre.com



 By Adrienne E. Frazior, J.D. Sidra S. Galvin, J.D. Polsinelli, PC
By Adrienne E. Frazior, J.D. Sidra S. Galvin, J.D. Polsinelli, PC

WhenBy Abhilasha Patel, M.D., Texas Oncology–Houston Willowbrook Radiation Oncology
WhenBy Abhilasha Patel, M.D., Texas Oncology–Houston Willowbrook Radiation Oncology











 By Michael Jones Ph.D
By Michael Jones Ph.D

















 By Grace S. Yung, CFP Midtown Financial Group, LLC
By Grace S. Yung, CFP Midtown Financial Group, LLC
















